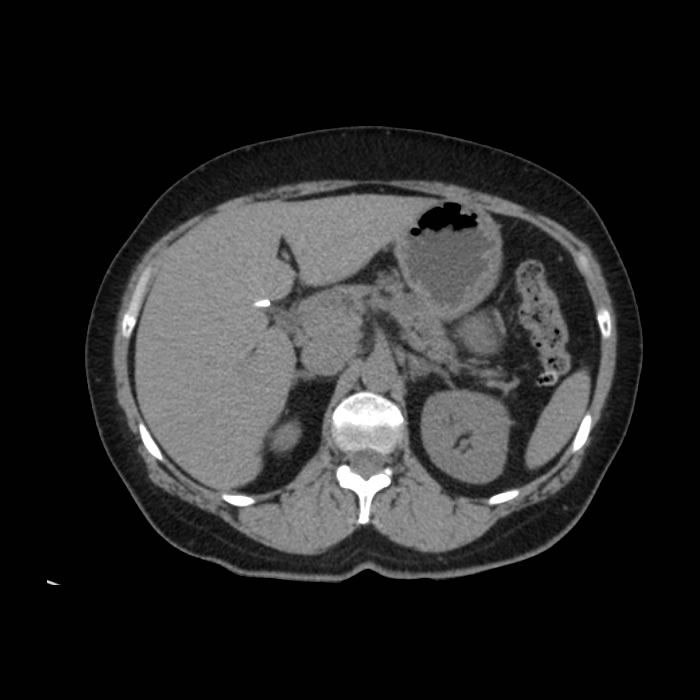

- Paciente de sexo femenino de 57 años de edad que acude a consulta por dolor abdominal irradiado hacia el flanco derecho. Al examen físico presenta abdomen blando con leve dolor a la palpación del marco colónico.
- Antecedentes de importancia: madre con antecedente de cáncer de colon.
- Antecedentes quirúrgicos: Colecistectomía, apendicectomía, cesáreas.